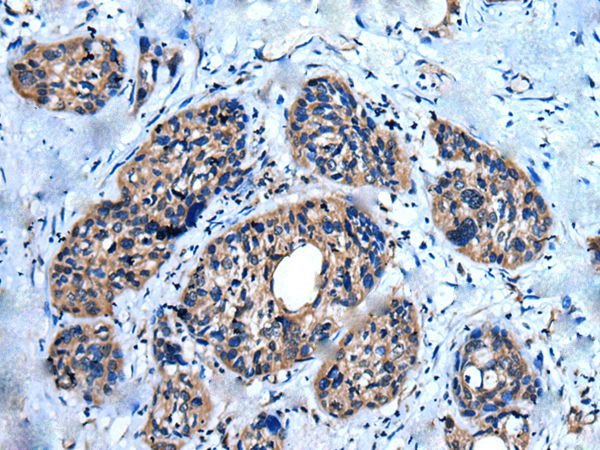
UNC5A Antibody in Immunohistochemistry (Paraffin) (IHC (P))

Search
Invitrogen
UNC5A Polyclonal Antibody
{{$productOrderCtrl.translations['antibody.pdp.commerceCard.promotion.promotions']}}
{{$productOrderCtrl.translations['antibody.pdp.commerceCard.promotion.viewpromo']}}
{{$productOrderCtrl.translations['antibody.pdp.commerceCard.promotion.promocode']}}: {{promo.promoCode}} {{promo.promoTitle}} {{promo.promoDescription}}. {{$productOrderCtrl.translations['antibody.pdp.commerceCard.promotion.learnmore']}}



Please note: We are reviewing Western blot images included in the antibody testing data in our catalog, including those provided by third parties. Unless expressly labeled or annotated as “raw-unedited”, Western blot images included in the antibody testing data in our catalog may have been edited, optimized or otherwise adjusted for presentation.
产品信息
PA5-67592
种属反应
宿主/亚型
分类
类型
抗原
偶联物
形式
浓度
规格
纯化类型
保存液
内含物
保存条件
运输条件
RRID
产品详细信息
Predicted to react with Mouse and Rat samples.
靶标信息
The UNC5H family of proteins act as transmembrane receptors for netrin-1 and play a crucial role in axon guidance and migration of neural cells. Additionally, when cleaved by a caspase to produce an intracellular fragment containing a death domain, UNC5H receptors induce apoptosis. This activity is blocked by the binding of netrin-1. In the absence of netrin-1, UNC5H receptors act as tumor suppressors by inhibiting anchorage-independent growth and invasion, but mutation of these receptors provides a potential mechanism for tumorigenicity. The expression of UNC5H receptors is downregulated in multiple carcinomas, including colorectal, breast, ovary, uterus, stomach, lung and kidney cancers. UNC5H1, also known as UNC5HA (unc-5 homolog A), is a member of the UNC5H family of proteins and is localized to the cell membrane. Three isoforms of UNC5H1 exist due to alternative splicing events.
仅用于科研。不用于诊断过程。未经明确授权不得转售。
篇参考文献 (0)
生物信息学
蛋白别名: Netrin receptor UNC5A; Protein unc-5 homolog 1; Protein unc-5 homolog A; transmembrane receptor Unc5H1; unc-5 homolog 1; unc5 homolog 1; UNC5H1FLJ16449
基因别名: KIAA1976; mKIAA1976; UNC5A; UNC5H1
UniProt ID: (Mouse) Q8K1S4, (Rat) O08721
Entrez Gene ID: (Mouse) 107448, (Rat) 60629